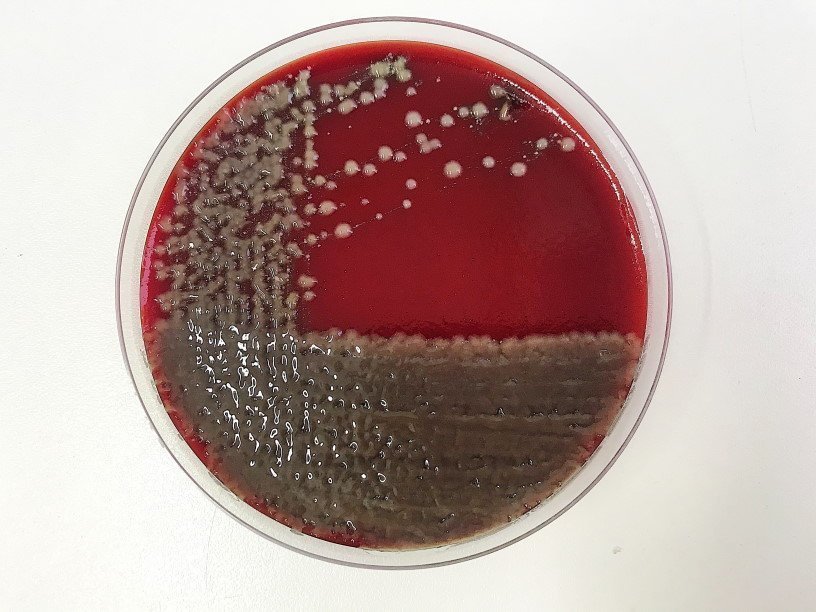

Екатерина Беленко: Промикробы: Повышенная влажность
Посев мокроты на микрофлору Фото: Екатерина Беленко
Посев мокроты на микрофлору Фото: Екатерина Беленко Сегодня предлагаю обсудить неаппетитную тему — посев мокроты. На фото именно этот анализ, полюбуйтесь — какая красотища! Посев мокроты на микрофлору и чувствительность к антибиотикам необходим для определения вида микроорганизма и выбора целенаправленной терапии. Основные показания к проведению этого анализа — это воспалительные заболевания респираторного тракта (пневмония, острые и хронические бронхиты, абсцесс легкого, и др.). Никак не горло болит аж два дня или ребенок кашлянул целых три раза.
⠀
Есть несколько вариантов добычи мокроты из пациента, самый простой — отхаркивание мокроты при кашле. Но этот метод, кроме явных достоинств, имеет и скрытые недостатки. Дело в том, что мокрота, проходя через верхние дыхательные пути и полость рта, может контаминироваться вегетирующей в них микрофлорой. Другими словами, путь мокроты до баночки далеко не стерилен, она может повстречать зеленящих стрептококков (Streptococcus viridans group), стафилококков (Staphylococcus еpidermidis), непатогенных нейссерий (Neisseria spр.), непатогенных дифтероидов (Corynebacterium sрp.), Lactobacillus spр., грибы рода Candida и других жильцов рта.
⠀
Поэтому дальнейшая работа микробиолога превращается в развлечения Золушки: попробуй отдели микрофлору самой мокроты от этих встреченных по пути бактерий! Порой их бывает так много, что за лесом не видно деревьев. После разделения этиологически значимых микроорганизмов от бактерий-контаминантов проводят количественный метод подсчета выделенных микроорганизмов. При этом учитывают, что возбудитель заболевания находится в исследуемом биологическом образце в существенно больших количествах по сравнению с бактериями-симбиотами. Считается, что для мокроты клинически значимым числом является 10 в 6 – 10 в 7 КОЕ/мл. Для бронхиальных смывов после бронхо-альвеолярного лаважа (не путать с лавашом) — 10 в 4 – 10 в 5 КОЕ/мл.
А еще, уж простите мне больничный снобизм, но все, что пациент делает самостоятельно, а не под присмотром врача, сопряжено с рисками. Велел врач собрать мокроту, пациент сидит с банкой наготове и ждет, когда ж засвербит в глубинах организма. И вот вроде засвербело, закашлял, но в банку попали одни лишь слюни. Поэтому для всех болеющих два совета: первый — выздоравливайте, второй — ждите сгустка, нет смысла сеять ваши слюни. Кроме того, накануне сбора мокроты пейте больше жидкости, чтобы самой мокроты было больше, а непосредственно перед сбором необходимо почистить зубы и прополоскать ротовую полость, чтобы хоть чуточку сократить количество обсеменителей. Есть способ достать мокроту с большим успехом, но и менее приятный для пациента — бронхоскопия. Не буду красочно описывать, стойкие духом могут погуглить. Процедура не самая приятная, врачи стараются избегать ее, пока есть такая возможность.
Смотрите также: Екатерина Беленко Промикробы: Все салаты подъедены Екатерина Беленко Промикробы: Скрытая угроза Екатерина Беленко Промикробы: Ода кишечной микрофлоре Екатерина Беленко Промикробы: Знакомьтесь, синегнойная палочка! Новое Татьяна Пигарева Испания от И до Я Сергей Сергеев Русское самовластие. Власть и ее границы: 1462–1917 гг. Катерина Михалева-Эгер 350 лет современной моды Леонид Чутко Сил нет Катя Колпинец Формула грез Сергей Плохий Забытые бастарды Восточного фронта Дэвид Чиверс, Том Чиверс Цифры врут. Как не дать статистике обмануть себя Пол Стейнхардт Невозможность второго рода Стивен Хоффман Пять сил, изменяющих все Уолтер Айзексон Взломавшая код Рустам Александер Закрытые. Жизнь гомосексуалов в СССР 3D-каркасы для восстановления костной ткани Платиновый бутерброд для спинтроники